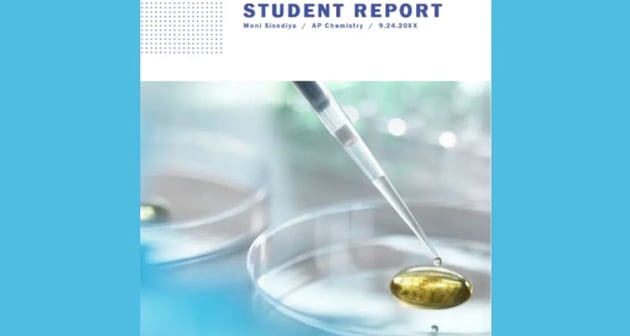
Classic students report

Report cover page templates can make or break your annual reports. Envato Elements offers the best cover page for reports for you to choose from. If this selection of report cover page templates isn't what you're looking for?
Head over to Envato Elements and choose the cover reports that best fit what you're going for.
20 Top Free Annual Report Front Cover Page Templates to Download (2024)
8 Best Annual Report Cover Designs for 2024 (Premium From Envato Elements)
You can use any free multipurpose report cover template to create annual report title pages. But lack of professional designs will lead you to create a report that's not impressive.
Work smart! Use premium professional annual report templates from Envato Elements. Get access to millions of premium creative files (including creative annual report cover ideas) with a low monthly fee. This subscription will help you improve all your creative work effortlessly.
Get your hands on the best annual report cover designs from Envato Elements! Premium designs for a low cost! Subscribe today!
Editorial Note: This article has been completely rewritten to make it more usable for the reader.